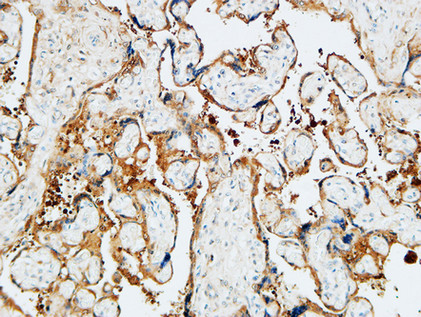
14 - TGase2 Polyclonal Antibody AP72808
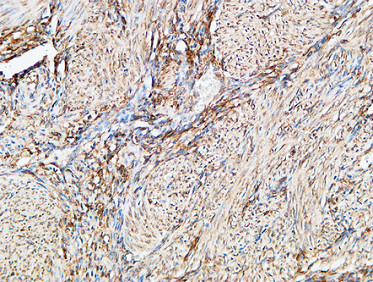
14 - TGase2 Polyclonal Antibody AP72808

TGase2 Polyclonal Antibody
- 产品详情
- 实验流程
- 背景知识
Application
| WB, IHC-P, IF, ICC, E |
|---|---|
| Primary Accession | P21980 |
| Reactivity | Human, Mouse |
| Host | Rabbit |
| Clonality | Polyclonal |
| Calculated MW | 77329 Da |
| Gene ID | 7052 |
|---|---|
| Other Names | TGM2; Protein-glutamine gamma-glutamyltransferase 2; Tissue transglutaminase; Transglutaminase C; TG(C); TGC; TGase C; Transglutaminase H; TGase H; Transglutaminase-2; TGase-2 |
| Dilution | WB~~Western Blot: 1/500 - 1/2000. Immunohistochemistry: 1/100 - 1/300. ELISA: 1/20000. Not yet tested in other applications. IHC-P~~Western Blot: 1/500 - 1/2000. Immunohistochemistry: 1/100 - 1/300. ELISA: 1/20000. Not yet tested in other applications. IF~~1:50~200 ICC~~N/A E~~N/A |
| Format | Liquid in PBS containing 50% glycerol, 0.5% BSA and 0.09% (W/V) sodium azide. |
| Storage Conditions | -20℃ |
| Name | TGM2 {ECO:0000303|PubMed:17939176, ECO:0000312|HGNC:HGNC:11778} |
|---|---|
| Function | Calcium-dependent acyltransferase that catalyzes the formation of covalent bonds between peptide-bound glutamine and various primary amines, such as gamma-amino group of peptide-bound lysine, or mono- and polyamines, thereby producing cross-linked or aminated proteins, respectively (PubMed:23941696, PubMed:31991788, PubMed:9252372). Involved in many biological processes, such as bone development, angiogenesis, wound healing, cellular differentiation, chromatin modification and apoptosis (PubMed:1683874, PubMed:27270573, PubMed:28198360, PubMed:7935379, PubMed:9252372). Acts as a protein- glutamine gamma-glutamyltransferase by mediating the cross-linking of proteins, such as ACO2, HSPB6, FN1, HMGB1, RAP1GDS1, SLC25A4/ANT1, SPP1 and WDR54 (PubMed:23941696, PubMed:24349085, PubMed:29618516, PubMed:30458214). Under physiological conditions, the protein cross- linking activity is inhibited by GTP; inhibition is relieved by Ca(2+) in response to various stresses (PubMed:18092889, PubMed:7592956, PubMed:7649299). When secreted, catalyzes cross-linking of proteins of the extracellular matrix, such as FN1 and SPP1 resulting in the formation of scaffolds (PubMed:12506096). Plays a key role during apoptosis, both by (1) promoting the cross-linking of cytoskeletal proteins resulting in condensation of the cytoplasm, and by (2) mediating cross-linking proteins of the extracellular matrix, resulting in the irreversible formation of scaffolds that stabilize the integrity of the dying cells before their clearance by phagocytosis, thereby preventing the leakage of harmful intracellular components (PubMed:7935379, PubMed:9252372). In addition to protein cross-linking, can use different monoamine substrates to catalyze a vast array of protein post-translational modifications: mediates aminylation of serotonin, dopamine, noradrenaline or histamine into glutamine residues of target proteins to generate protein serotonylation, dopaminylation, noradrenalinylation or histaminylation, respectively (PubMed:23797785, PubMed:30867594). Mediates protein serotonylation of small GTPases during activation and aggregation of platelets, leading to constitutive activation of these GTPases (By similarity). Plays a key role in chromatin organization by mediating serotonylation and dopaminylation of histone H3 (PubMed:30867594, PubMed:32273471). Catalyzes serotonylation of 'Gln-5' of histone H3 (H3Q5ser) during serotonergic neuron differentiation, thereby facilitating transcription (PubMed:30867594). Acts as a mediator of neurotransmission-independent role of nuclear dopamine in ventral tegmental area (VTA) neurons: catalyzes dopaminylation of 'Gln-5' of histone H3 (H3Q5dop), thereby regulating relapse-related transcriptional plasticity in the reward system (PubMed:32273471). Regulates vein remodeling by mediating serotonylation and subsequent inactivation of ATP2A2/SERCA2 (By similarity). Also acts as a protein deamidase by mediating the side chain deamidation of specific glutamine residues of proteins to glutamate (PubMed:20547769, PubMed:9623982). Catalyzes specific deamidation of protein gliadin, a component of wheat gluten in the diet (PubMed:9623982). May also act as an isopeptidase cleaving the previously formed cross-links (PubMed:26250429, PubMed:27131890). Also able to participate in signaling pathways independently of its acyltransferase activity: acts as a signal transducer in alpha-1 adrenergic receptor-mediated stimulation of phospholipase C-delta (PLCD) activity and is required for coupling alpha-1 adrenergic agonists to the stimulation of phosphoinositide lipid metabolism (PubMed:8943303). |
| Cellular Location | Cytoplasm, cytosol. Nucleus. Chromosome. Secreted, extracellular space, extracellular matrix. Cell membrane {ECO:0000250|UniProtKB:Q9WVJ6}. Mitochondrion. Note=Mainly localizes to the cytosol (PubMed:9575137). Present at much lower level in the nucleus and chromatin (PubMed:9575137). Also secreted via a non-classical secretion pathway to the extracellular matrix (PubMed:27270573) |
Research Areas
For Research Use Only. Not For Use In Diagnostic Procedures.
Application Protocols
Provided below are standard protocols that you may find useful for product applications.
BACKGROUND
Catalyzes the cross-linking of proteins and the conjugation of polyamines to proteins.
终于等到您。ABCEPTA(百远生物)抗体产品。
点击下方“我要评价 ”按钮提交您的反馈信息,您的反馈和评价是我们最宝贵的财富之一,
我们将在1-3个工作日内处理您的反馈信息。
如有疑问,联系:0512-88856768 tech-china@abcepta.com.
¥ 1,500.00
Cat# AP72808























 癌症的基本特征包括细胞增殖、血管生成、迁移、凋亡逃避机制和细胞永生等。找到癌症发生过程中这些通路的关键标记物和对应的抗体用于检测至关重要。
癌症的基本特征包括细胞增殖、血管生成、迁移、凋亡逃避机制和细胞永生等。找到癌症发生过程中这些通路的关键标记物和对应的抗体用于检测至关重要。 为您推荐一个泛素化位点预测神器——泛素化分析工具,可以为您的蛋白的泛素化位点作出预测和评分。
为您推荐一个泛素化位点预测神器——泛素化分析工具,可以为您的蛋白的泛素化位点作出预测和评分。 细胞自噬受体图形绘图工具为你的蛋白的细胞受体结合位点作出预测和评分,识别结合到自噬通路中的蛋白是非常重要的,便于让我们理解自噬在正常生理、病理过程中的作用,如发育、细胞分化、神经退化性疾病、压力条件下、感染和癌症。
细胞自噬受体图形绘图工具为你的蛋白的细胞受体结合位点作出预测和评分,识别结合到自噬通路中的蛋白是非常重要的,便于让我们理解自噬在正常生理、病理过程中的作用,如发育、细胞分化、神经退化性疾病、压力条件下、感染和癌症。